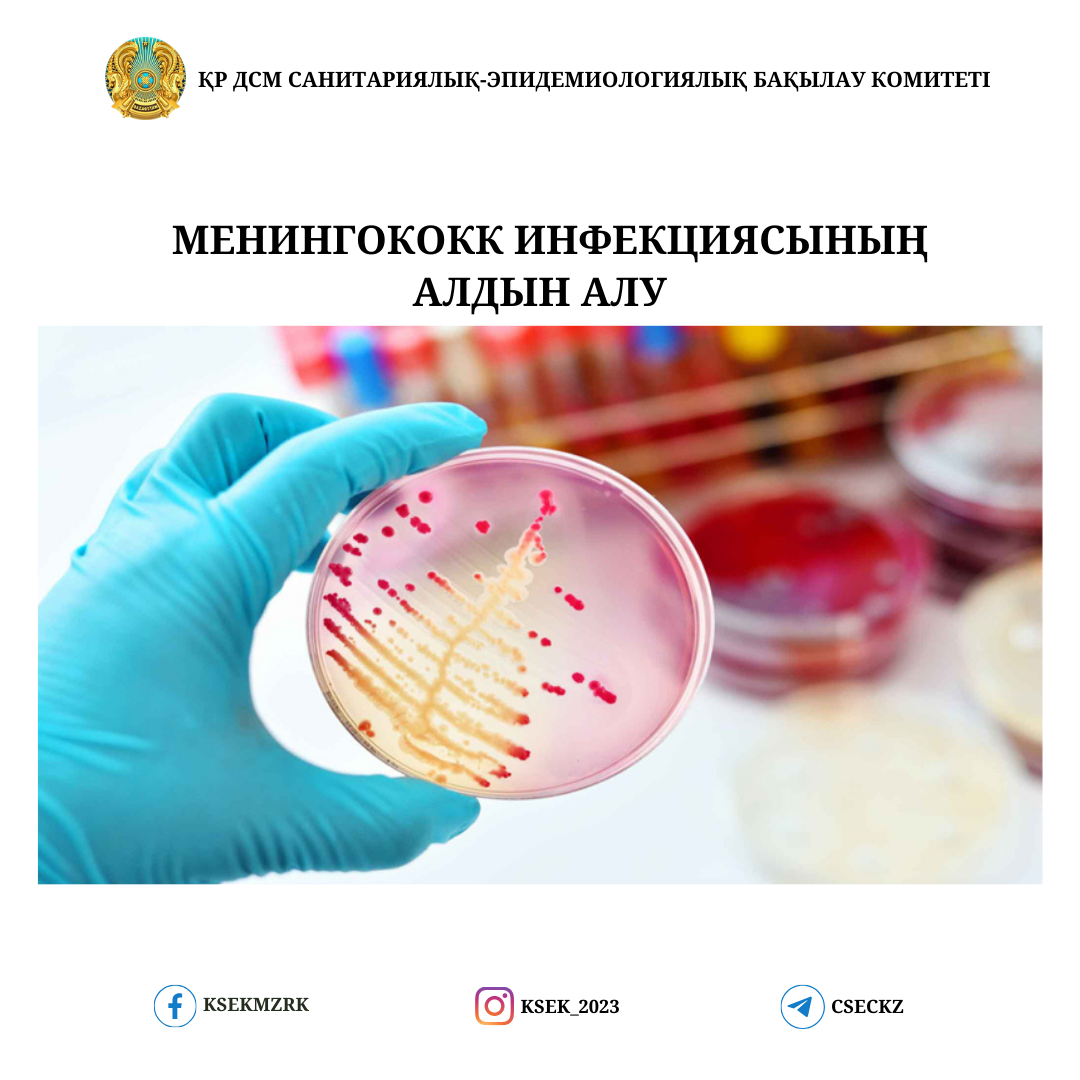
Мүмкіндігі шектеулі адаммен жыныстық қатынасқа түсу

Порно индустриясында бірегей эротикалық материалдар, мен ұзақ мерзімді интимдік бақыт. Әлеуметтік желі мен медиа Өзіңіз бөртпе жасаңыз ашық әрі сауатты бола бастауының. Мамандардың пікірінше, ересектерге арналған қысқа видео материалдар, жаңа порно оқиғалар, индивидуалды сексуалдық қажеттіліктерді түсіну басты қиял туралы кеңес маңызды.